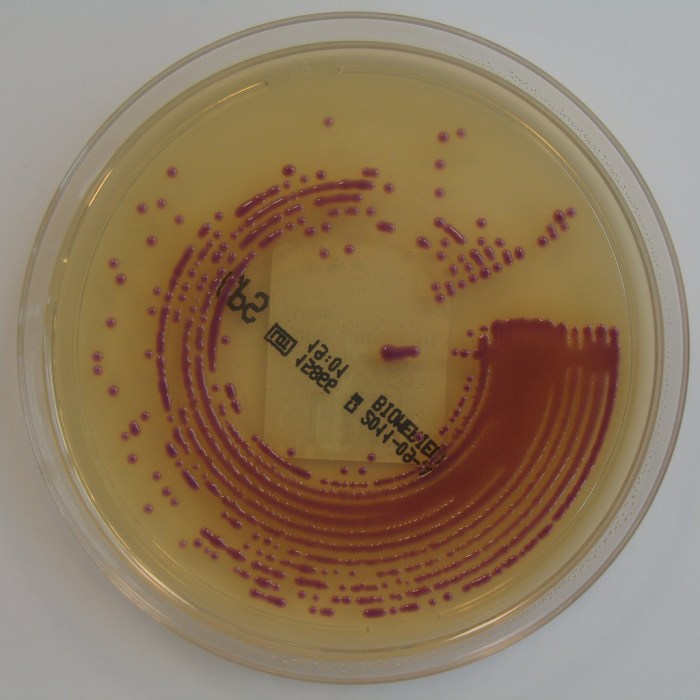

I’ve written this post in preparation for next week’s Journal Club in partnership with the Healthcare Infection Society themed around their MRSA article collection: “MRSA: the enduring foe”. Having spent a fair bit of time this week looking at post-infection reviews related to MRSA bloodstream infections, I can vouch for how well this particular foe has endured, even in a relatively low prevalence setting!
Continue readingcost-effectiveness
Formatting scientific papers: a waste of time, money, and grey matter!
Those of you who have published a scientific paper or two will recognise the following process:
Format.
Submit.
Reject.
Reformat.
Submit.
Reject.
Reformat.
Submit.
Accept.
By the end of this process, not only have you lost the will to live (or ever reformat a scientific paper ever again), you’ve also wasted time = money. And chances are, the money has been entrusted to you to perform research, not reformat documents! A recently study counts the cost of this process, concluding that the average scientist spends 52 hours per person per year on formatting / reformatting scientific papers, with a cost of around $500 USD per manuscript or ~$2k per year.
Cheap and slow (culture) is usually better than fast and expensive (PCR) for CPE screening: Bertha says so!
BMC Medicine has published some research from our group reporting the findings of a mathematical model comparing various approaches to screening for CPE carriage. The model compared how several operational metrics varied with different approaches to screening (‘slow and cheap’ laboratory culture vs. ‘fast and expensive’ PCR) and in various specialties with variable levels of compliance with CPE admission screening and at various levels of admission prevalence of CPE. The main conclusion was that culture proved to be the best approach in most scenarios, balancing risk and resource.
Keeping hospitals clean and safe without breaking the bank
A paper has just been published in ARIC as the first academic output of the Healthcare Cleaning Forum. I blogged earlier this year to relate the inaugural Healthcare Cleaning forum, and this paper expands on the key themes: establishing environmental hygiene as a patient safety initiative, providing an overview of the importance of environmental hygiene in healthcare, exploring the human factors driving the standards of environmental hygiene along with the need for effective education, the possibilities and challenges of automation, and the cost and value of environmental hygiene.
One of the key aims of the forum is to be a champion for environmental hygiene professionals. There’s a famous story of when president JFK visited NASA and asked a janitor who was mopping the floor what they were doing. The answer was simple and profound: “I’m helping to put a man on the moon.” If you asked somebody working in environmental hygiene in your hospital what they were doing, would the response be: “I’m helping to maximise patient safety and prevent healthcare-associated infection.” Probably not. We need to champion the cause of environmental hygiene professionals, who lack professional status, are often not paid enough, and often have limited options for career progression.
Is environmental a treasured investment priority in hospitals?
Related to this is our perception of the cost and value of environmental hygiene in hospitals. Is our level of investment appropriate given the risks associated with inadequate environmental hygiene in hospitals? Would we really find highly valued cleaning and disinfection materials in the metaphorical safe of a hospital manager (see the cartoon above)? Probably not! We need work towards better evidence to understand the value of environmental hygiene in hospitals in the context of other investment priorities.
Evaluating the value of multidisciplinary reviews to get to the root causes of C. difficile infection
An interesting paper has been published evaluating the cost and value of multidisciplinary team (MDT) meetings to investigate C. difficile cases. The study counts the cost of C. difficile MDTs (somewhere between £25k and £50k over two years), and concludes that they had limited value in delivering additional learning or quality improvement. But I beg to differ…!
The inaugural Healthcare Cleaning Forum
Today was the inaugural Healthcare Cleaning Forum. The plan was to showcase some healthcare cleaning and disinfection science at the Interclean Conference in Amsterdam (which is a huge general cleaning show). I think we managed to create some awareness about the unique challenges of cleaning and disinfection in healthcare outside of the usual crowd.
Effective stewardship: less antibiotic use and more hand hygiene
Rossana Rosa (bio below) writes a guest post, reflecting on this recent review and meta-analysis on the effectiveness of antimicrobial stewardship (AMS) programmes…
The first reports on the effects of Antimicrobial Stewardship Programmess date back to the mid-90s, and the interest in them has taken off in the past decade.
A health economist’s guide to the AMS galaxy
Guest blogger Nikki Naylor (bio below) has written this post about a recent review on the cost-effectiveness of antimicrobial stewardship…
I’ll start this blog post off with a promise – I promise not to use any equations or unnecessarily complex terms that just describe logical concepts (something us economists do like to do on occasion). In return, I hope that you will see past the standard and not-to-exhilarating conclusion of “more evidence is needed” and see some of the more useful messages that sit within this recent review that we have published.
The ethics of MDRO screening
I heard an interesting talk by Dr Michael Miller last week on the ethics of screening for MDROs. Whilst we need to think carefully about the ethics of all medical procedures (great and small), I think the benefits to the individual and the population generally outweigh downsides for MDRO screening programmes.
CPE screening Q&A: the who, when, and how
I gave a talk yesterday as part of a PHE London event on the whys and wherefores of screening for MDROs – my talk was focussed on CPE, and you can download my slides here: “CPE: seek and ye shall find”. I thought a quick Q&A would be the best way to summarise the content.